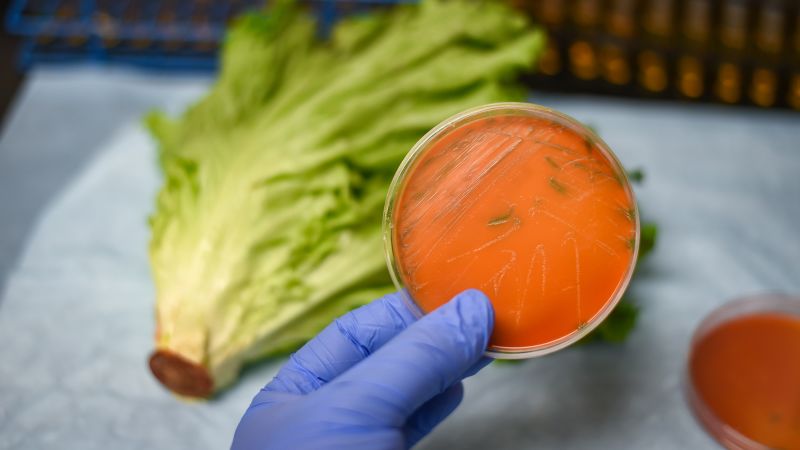

Recent Food and Beverage Guidelines Spark Consumer and Industry Changes
The 2025-2030 US dietary guidelines recommend more protein and full-fat dairy, and explicitly advise avoiding ultraprocessed foods, but the development process for these guidelines was unconventional and may lack scientific rigor, raising questions about their reliability.